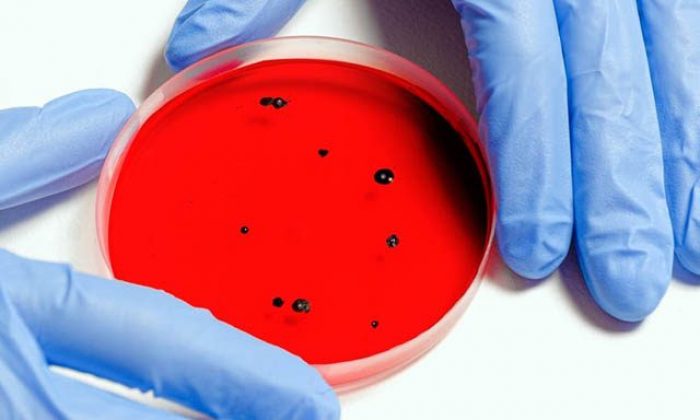
Mutasyon ve mutasyon hakkında merak edilenler

Mutasyon ve mutasyon hakkında merak edilenler
Koronavirüs mutasyonunun gündemde yer almasının ardından konu ila ilgili araştırmalar hızlandı. İngiltere’de koronavirüsün mutasyona uğradığı haberi verildi. Kovid-19’un mutasyona uğramasının ardından daha hızlı yayılabildiği açıklandı. İşte mutasyon kelimesinin anlamı ve koronavirüs mutasyonu hakkında bilgiler
Mustasyon kelimesi gündemde yer alıyor. İngiltere’de ortaya çıkan koronavirüs mutasyonunun ardından vatandaşlar bu kelimenin anlamını araştırmaya başladılar. RNA virüslerinde DNA virüslerine oranla çok daha fazla mutasyon meydana geliyor. Enfeksiyon Hastalıkları Uzmanı Dr. Songül Özer, mutasyona ilişkin kafa karıştıran temel soruları Hürriyet Aile okurları için cevapladı.
MUTASYON NEDİR?
Sağlık Bakanlığı’nın yayımladığı COVID-19 Sözlüğü’nde yer alan bilgilere göre mutasyon;
Bir organizmanın veya virüsün genetik materyalinde meydana gelen kalıcı değişiklik.
RNA virüslerinde DNA virüslerine oranla çok daha fazla mutasyon meydana gelir. SARS-CoV-2 bir RNA virüsüdür.
Mutasyon ya da değişinim, bir canlının genomu içindeki DNA ya da RNA diziliminde meydana gelen kalıcı değişmelerdir. Mutasyona uğramış organizma ise mutant olarak adlandırılır. Mutasyonların genler üzerindeki zararlı etkileri nedeniyle, organizmalar mutasyonları gidermek için DNA onarımı gibi mekanizmalara sahiptir.
KORONAVİRÜS MUTASYONU HAKKINDA MERAK EDİLENLER
Enfeksiyon Hastalıkları Uzmanı Dr. Songül Özer, mutasyona ilişkin kafa karıştıran temel soruları Hürriyet Aile okurları için cevapladı.
MUTASYONA UĞRAYAN KORONAVİRÜS DAHA MI TEHLİKELİ?
Bütün virüslerde mutasyona uğrama yani ‘varyant değiştirme’ ihtimali var. Bazı virüslerde bu ihtimal daha yüksek oluyor. Influenza ve koronavirüste daha sık ve daha kısa sürede mutasyon gerçekleşebiliyor. Antijenik değişikliği her zaman kötü yönde değerlendirmemek gerekiyor. Virüs antijenik yapısını değiştirdi, yeni bir suç meydana getirdi, şimdi daha çok ölüm olacak veya daha çok yayılacak diye korkulmamalı. Bazen virüsteki antijenik yapı değişikliği aksine iyi yönde de olabiliyor. Gerçekleştirilen çalışmalar doğrultusunda yapılan açıklamalarda, yeni saptanan virüsün bulaştırıcılığının daha yüksek olduğu ama hastalar arasında fatalite dediğimiz ölüme neden olma ya da ağır hastalık tabloları oluşma ihtimalinin daha az olduğu bilgisi veriliyor. Aslında bu iyi bir durum. Daha çok bulaşması demek onun daha kötü olduğu anlamına gelmiyor. Hastaların ağır geçirmesi ya da hastaların ölüme sebebiyet vermesi bizi ilgilendiriyor. Çok kişiye bulaşabilir ama hafif geçirebilirler. Toplumdaki bağışıklığın artmasını sağlayacağı için bir anlamda iyi bir durum bu. Hasta olup da atlatanların sayısı artınca doğal olarak aşılanmış gibi olurlar. Hastalığı geçirerek bağışık kazanırlar ki aktif bağışıklama dediğimiz bu tablo en çok istenen tablodur.

